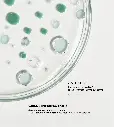
VISUEL-ACTIFS-COEUR_DE_FORMULE-PURE.webp

Rutina Piel Grasa / Anti-Imperfecciones – Línea PURE de Patyka
Este pack está diseñado para tratar la piel grasa y con imperfecciones de forma eficaz, respetuosa y equilibrada.
Incluye una rutina completa con 3 pasos esenciales:
✨ Gel Limpiador Purificante
Limpia en profundidad, elimina el exceso de grasa y purifica la piel sin resecarla.
✨ Sérum Intensivo Anti-Imperfecciones
Actúa directamente sobre granitos, poros y marcas, ayudando a regular el sebo y mejorar la textura de la piel.
✨ Fluido Matificante Anti-Imperfecciones
Hidrata, matifica y equilibra la piel durante el día, reduciendo brillos y previniendo nuevas imperfecciones.
💚 ¿Qué consigue esta rutina?
✔️ Menos brillos y exceso de grasa
✔️ Reducción de imperfecciones
✔️ Poros más afinados
✔️ Piel más uniforme y equilibrada
🎯 ¿Para quién es?
- Piel grasa o mixta
- Piel con tendencia acneica
- Personas con poros visibles o brillos
Este contenido se compartirá a través de todas las páginas de productos.